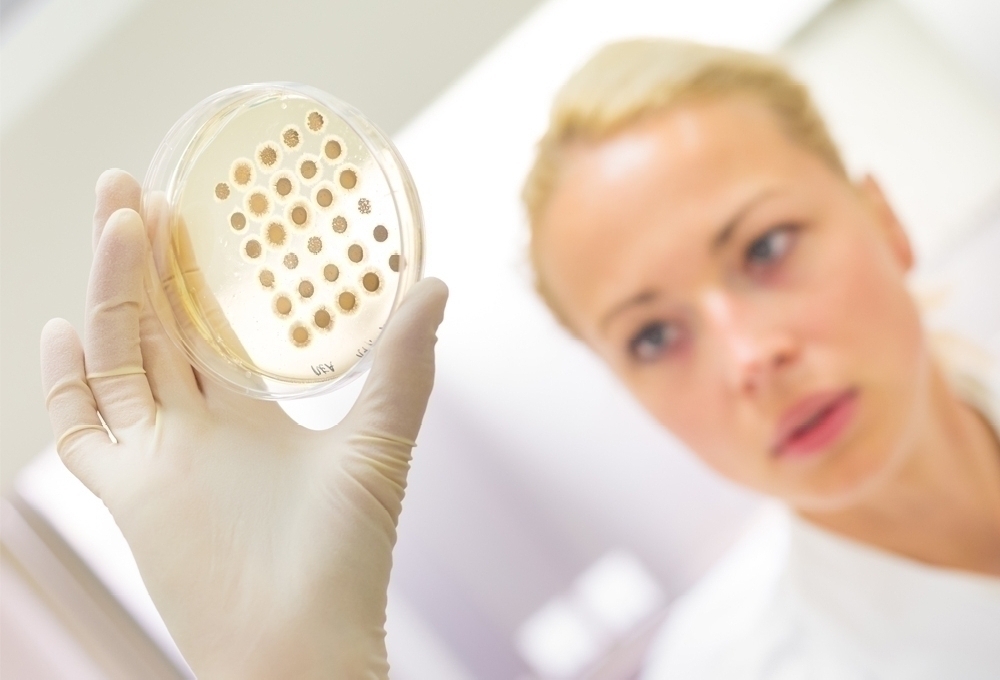

Medical
MEDICAL – Alles für Hygiene, Sicherheit und Ausstattung im Arbeitsalltag
In unserer Kategorie MEDICAL bieten wir Ihnen eine umfassende Auswahl an hochwertigen Produkten, die speziell für den Einsatz in medizinischen und hygienerelevanten Bereichen entwickelt wurden. Egal ob in der Pflege, in Kliniken, Laboren oder anderen professionellen Umfeldern – bei uns finden Sie die passende Ausstattung, die Sie bei Ihrer Arbeit unterstützt.
Unser Sortiment im Überblick:
Desinfektion & Reinigung: Effektive Lösungen für hygienisch einwandfreie Arbeitsbereiche, von Desinfektionsmitteln bis zu Reinigungssystemen.
Arbeitsplatzausstattung & Zubehör: Praktische und funktionelle Produkte, die den Arbeitsalltag erleichtern – von Spendern und Halterungen bis hin zu speziellen Aufbewahrungslösungen.
Einwegbekleidung: Hygienische Einwegartikel wie Schutzkittel, Hauben oder Überschuhe, die für höchste Sauberkeit und Schutz sorgen.
Einmalhandschuhe: Eine große Auswahl an hochwertigen Handschuhen für Einmalgebrauch, ideal für den Einsatz in sensiblen Bereichen.
Mit unseren Produkten garantieren wir Ihnen Qualität, Zuverlässigkeit und eine perfekte Abstimmung auf die Anforderungen des modernen Arbeitsalltags. Entdecken Sie jetzt unsere vielfältige Auswahl in der Kategorie MEDICAL und rüsten Sie sich optimal für Ihre täglichen Herausforderungen aus.
